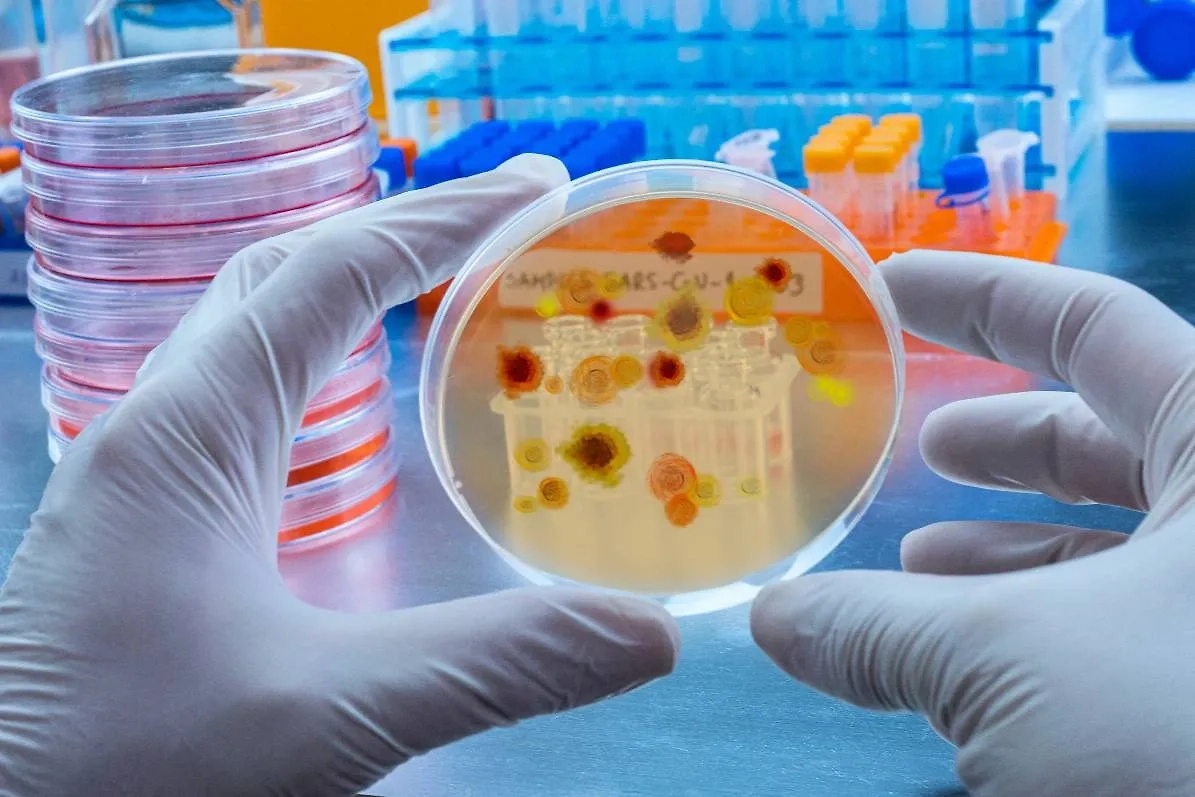
Около 600 вирусов живут на зубных щётках, душевых лейках. Фото © Shutterstock / FOTODOM / felipe caparros
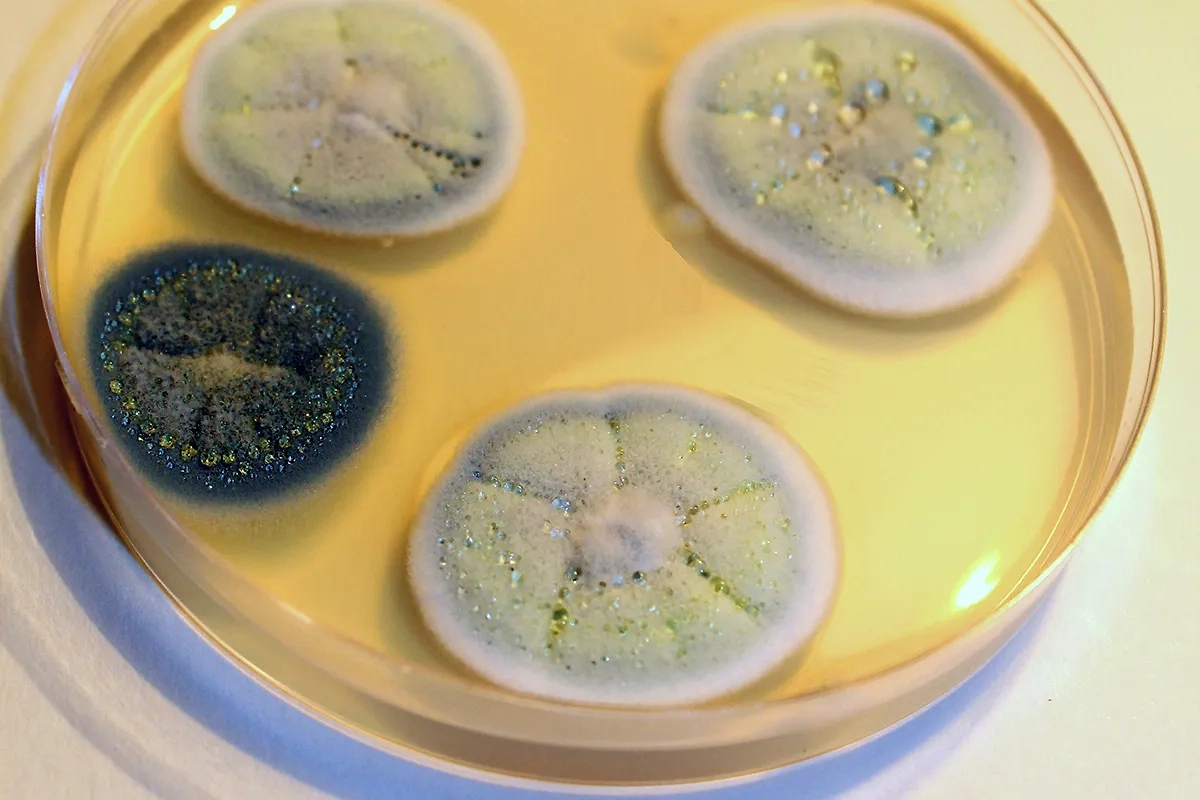
Плесневый гриб пеницилл. Фото © Wikipedia / Convallaria majalis

Гангстеры микромира: откуда на душевой лейке и зубной щётке взялось 600 вирусов
Вирусолог рассказал Life.ru, чем на самом деле интересно неожиданное открытие «дикого» количества неизвестных науке организмов на привычных в доме предметах.

Вирусолог объяснил, надо ли бояться многочисленных вирусов, обитающих в ванной комнате. Коллаж © Life.ru. Обложка © Shutterstock / FOTODOM / solarseven, VladKK
Обнаруженные недавно многочисленные вирусы из ванных комнат не представляют никакой опасности для людей и даже могут оказаться очень полезными, заверил Life.ru руководитель лаборатории особо опасных инфекций Федерального исследовательского центра фундаментальной и трансляционной медицины, доктор биологических наук Александр Чепурнов.
Ранее американские учёные открыли около 600 вирусов, которые процветают в том числе на зубных щётках, душевых лейках, а также дверных ручках и других бытовых поверхностях. По словам исследователей, многие из этих вирусов оказались неизвестными науке, а их количество — «абсолютно дикое». При этом абсолютное их большинство — так называемые бактериофаги, то есть вирусы, заражающие микробы.
Около 600 вирусов живут на зубных щётках, душевых лейках. Фото © Shutterstock / FOTODOM / felipe caparros
— Для человека это совершенно безвредная вещь, потому что бактериофаги специализируются именно на бактериях, — объясняет профессор Чепурнов.
Он рассказал, что паразитирующие в микробах вирусы встречаются повсеместно на планете, это часть естественного природного круговорота: вирусы препятствуют размножению бактерий. Доктор биологических наук привёл в пример Мировой океан: в каждом кубическом метре его воды — миллиарды бактерий, которые постоянно размножаются, но одновременно их стремительно убивают бактериофаги.
— Если бы это гигантское количество бактерий, которое там живёт, жило само по себе (без «врагов». — Прим. Life.ru) столько, сколько потенциально может прожить бактерия, то для их развития и размножения не хватало бы органического материала. Но наличие ещё более гигантского количества бактериофагов, нацеленных именно на эти бактерии, а их там прорва, препятствует этому, — подчеркнул вирусолог.
Он также отметил, что до открытия первого антибиотика в 1928 году бактериофаги очень активно изучали как потенциальное средство борьбы с болезнетворными бактериями. По его словам, на основе бактериофагов создавали препараты от самых разных инфекций, в том числе, к примеру, от чумы: у этой бактерии тоже есть свои «враги» (вирусы), которые внедряются в неё и убивают.
Напомним, первый антибиотик был создан на основе пенициллина — вещества, которое выделяет плесневый гриб пеницилл. С тех пор бактерицидные лекарства стали создавать именно на основе веществ из грибных культур. О возможностях вирусов-бактериофагов забыли, посетовал Александр Чепурнов, но сейчас самое время о них вспомнить.
Плесневый гриб пеницилл. Фото © Wikipedia / Convallaria majalis
— Мы исчерпываем потенциал антибиотиков. Формируется большое количество устойчивых к антибиотикам бактерий по разным направлениям, актуальным для нас, в частности лёгочных бактерий. И поскольку такая устойчивость всё сильнее себя проявляет, особенно из-за неправильного, избыточного применения антибиотиков, то, возможно, нам придётся вернуться к бактериофагам как к средству борьбы с бактериями, — заключил Александр Чепурнов.


